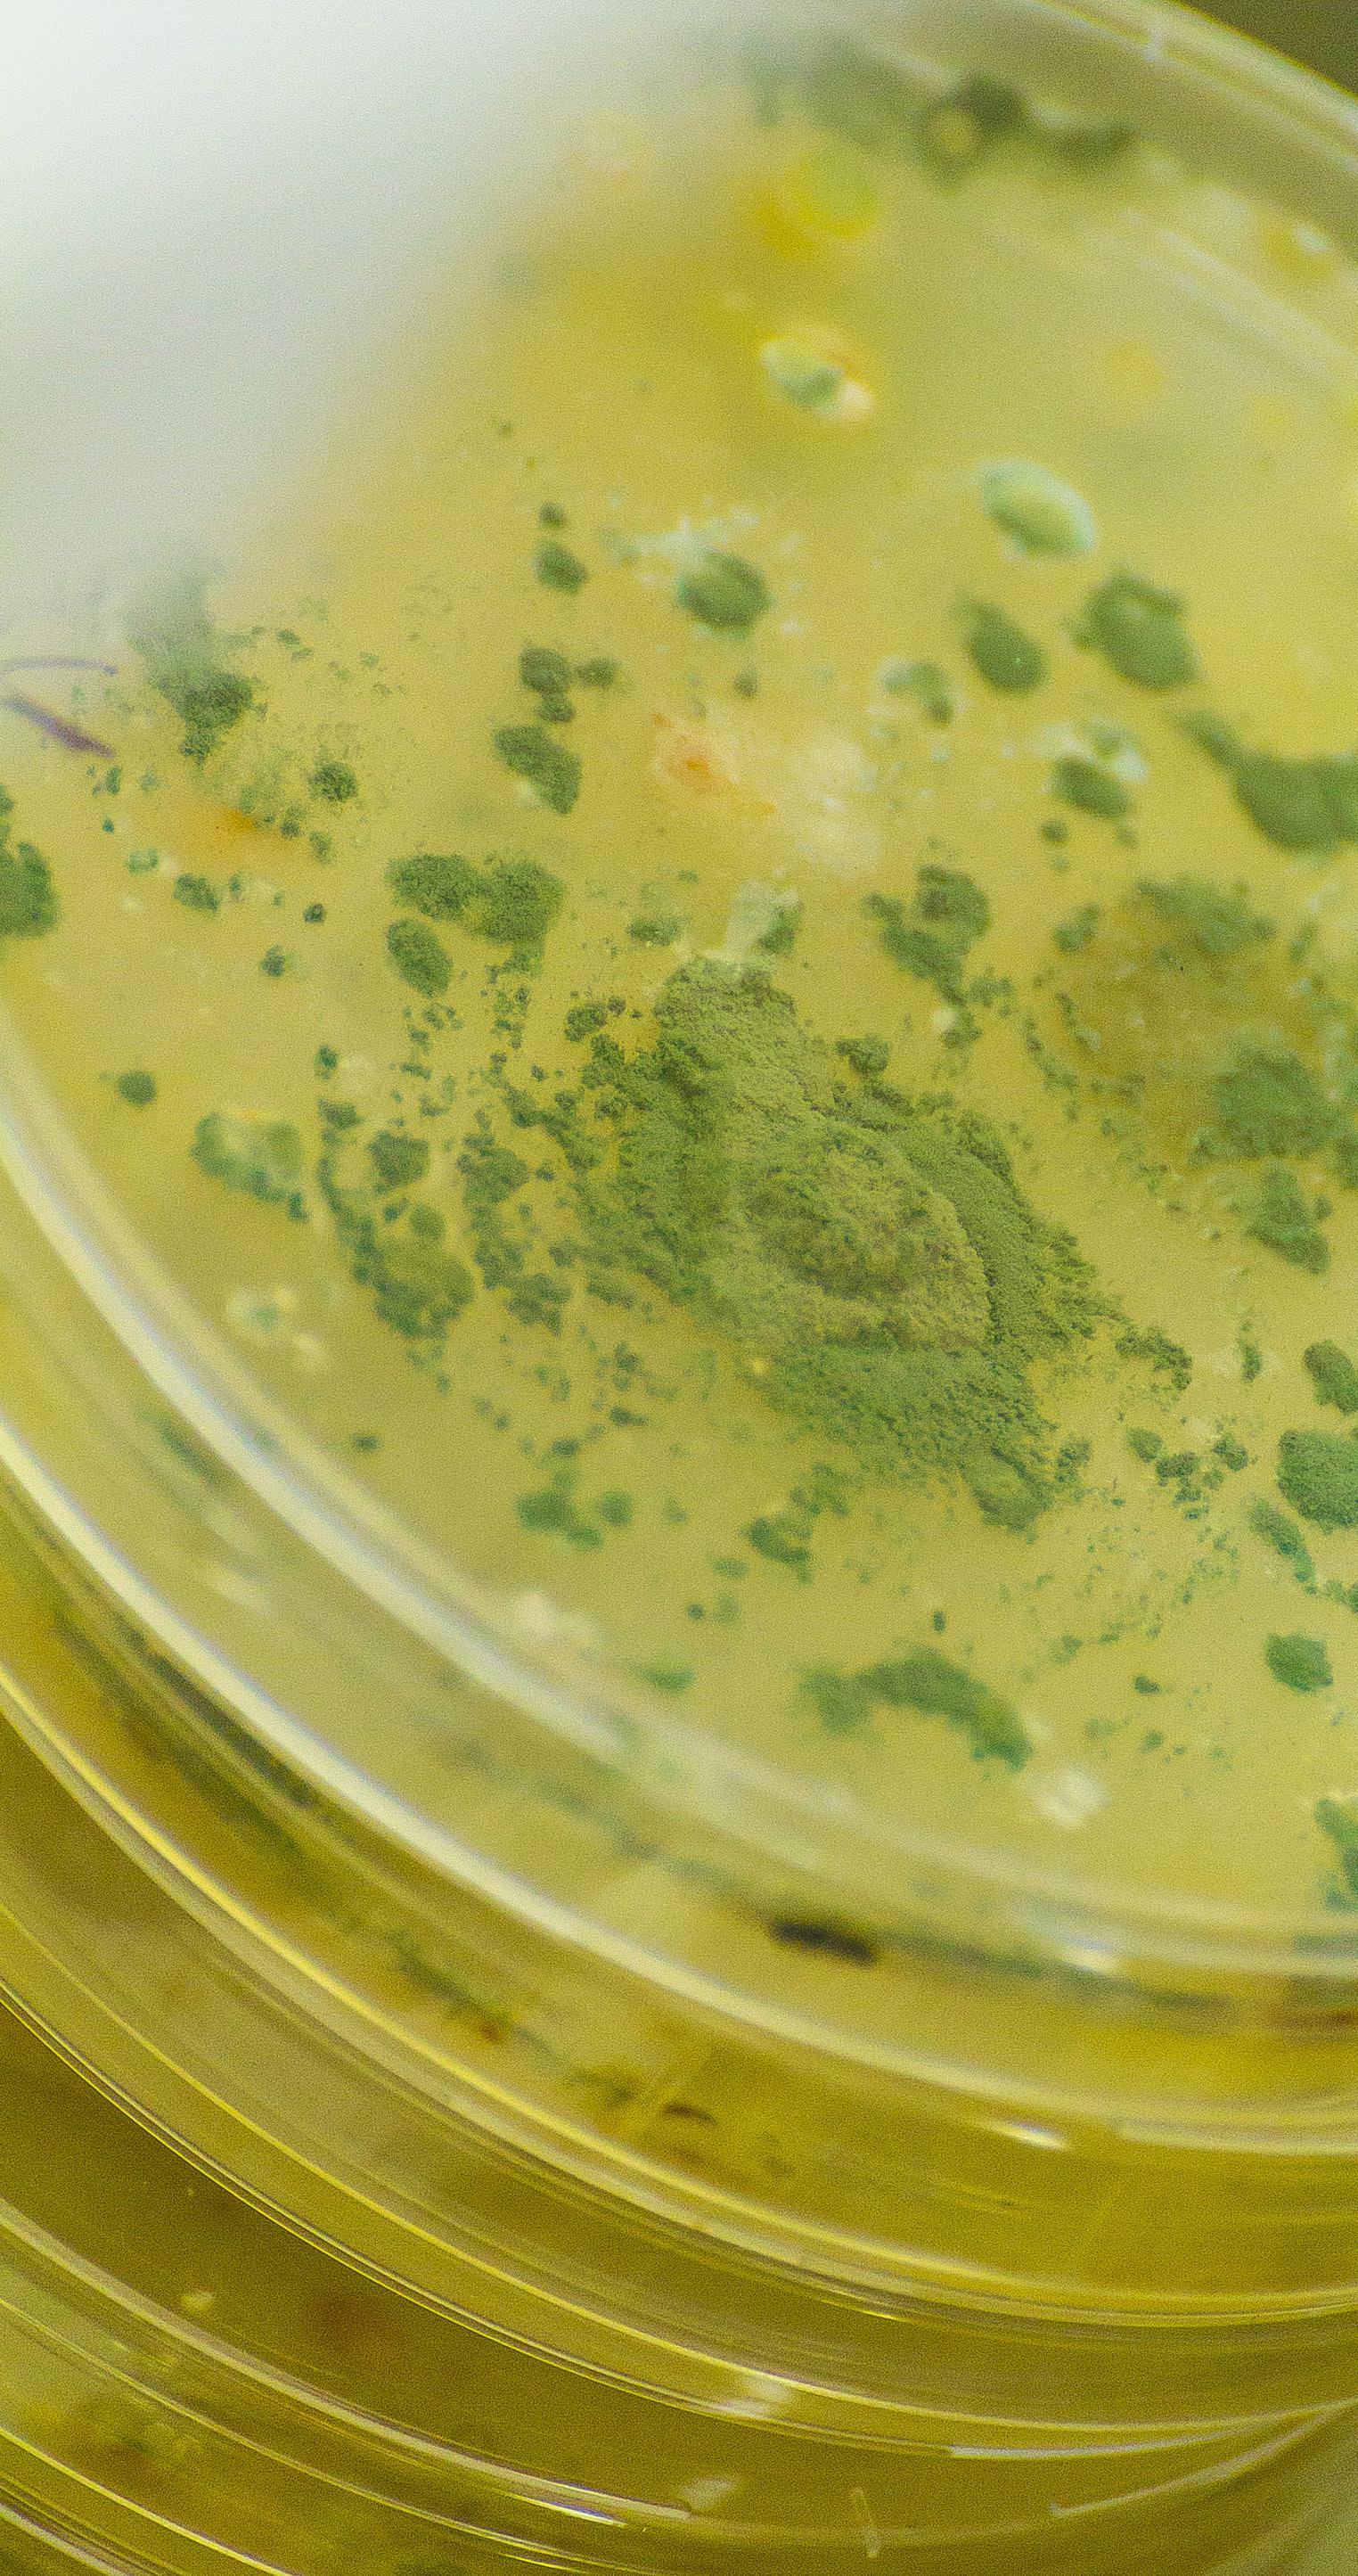

MAIN FUNGI AND MYCOTOXINS IN OATS
Fusarium
Fusarium is the most common mold on oats and it is responsible for the disease known as “Fusarium Head Blight”
The production of its mycotoxins is strongly influenced by climatic conditions and therefore varies according to the growing region4
The most relevant Fusarium mycotoxins in oats include:
Zearalenone (ZEN)
Fumonisins (mainly B1)
Trichothecenes type A and B
Among type A trichothecenes are T-2, HT-2 and diacetoxyscirpenol (DAS) toxins are noteworthy.
Among type B trichothecenes are deoxynivalenol (DON) and nivalenol (NIV). In addition, some glycosylated forms, such as DON-3-glucoside (DON-3-G) and T-2-glucoside, may be present5,6,7,8
Studies in Sweden, Finland, Poland, Norway, Canada, and Spain have shown increased contamination by DON and its derivatives (15-acetyl-DON, 3-acetyl-DON, and DON-3-G), ZEN, NIV, and fumonisin B1 (FB1)7,9,10,11,12,13
On the other hand, in countries such as the United Kingdom, Ireland, Czech Republic and Switzerland, type A trichothecenes and their glycosylated forms are predominant, due to the variability in the Fusarium species present in each region5,6,14,15
Emerging Fusarium mycotoxins, such as enniatins, beauvericin, fusaric acid and fusarenon-X, can also be detected in oats.
Studies in the Republic, Sweden, and Ireland have identified a significant presence of beauvericin and enniatin B, correlated with high levels of NIV5,10,14
DON and its derivatives
Type A trichothecenes and their glycosylated forms
Beauvericin, enniatin B and NIV
(15-acetyl-DON, 3-acetylDON, and DON-3-G), ZEN, NIV, and fumonisin B1 (FB1)
Alternaria
Alternaria mycotoxins have been less studied, but have also been found in oats and may pose a health risk.
These include16:
Alternariol (AOH)
Alternariol monomethyl ether (AME)
Tentoxin (TEN)
Tenuazonic acid (TeA)
The content of AOH in oats has been found to be higher than that of other cereals such as wheat and barley.
Likewise, the content of TEN is high in oats, similar to that of wheat, and its combination with TeA is frequent
Penicillium and Aspergillus
Penicillium and Aspergillus mycotoxins often appear in oats after harvest.
Penicillium mainly produces ochratoxins, such as ochratoxin A (OTA) and ochratoxin B (OTB), while Aspergillus can also produce ochratoxins, although it is best known for producing aflatoxins.
However, these mycotoxins rarely reach levels of concern in oats used in animal feed5,7,19
Sterigmatocystin, an emerging mycotoxin produced by Aspergillus, has occasionally been detected in oats, although at low frequency5
Studies in Russia, Norway and Latvia have identified a high incidence of this fungus and its mycotoxins in oat samples16,17,18
Table 1. Incidence, maximum value and country of detection of different mycotoxins of Fusarium, Alternaria, Penicillium and Aspergillus in samples of feed or raw materials analyzed in different European studies. ND: not available. DON: deoxynivalenol; ZEN: zearalenone; OTA: ochratoxin A; AOH: alternariol; AME: alternariol methyl ether; TEN: tentoxin; TeA: tenuazonic acid; OTB: ochratoxin B; DAS: diacetoxyscirpenol.
Fusarium mycotoxins: type A trichothecenes
Fusarium mycotoxins: type B trichothecenes
Fusarium mycotoxins: fumonisins Fusarium mycotoxins:
Fusarium mycotoxins
Alternaria mycotoxins
Penicillium and Aspergillus mycotoxins
MYCOTOXIN REGULATION IN ANIMAL FEED
Limits and recommendations for mycotoxins in feed are established in various European Union (EU) directives and recommendations:
Commission Directive 2003/100/EC of 31 October 2003 amending Annex I to Directive 2002/32/EC of the European Parliament and of the Council on undesirable substances in animal feed.
This includes a maximum limit for aflatoxin B1 (AFB1) in these products20
Commission Recommendation of August 17, 2006, on the presence of DON, ZEN, OTA and fumonisins in products intended for animal feed21
Commission Recommendation of 4 November, 2013, amending Recommendation 2006/576/ EC as regards T-2 and HT-2 toxins in feed22
Commission Recommendation (EU) 2016/1319 of 29 July, 2016, amending Recommendation 2006/576/ EC as regards DON, ZEN, and OTA in pet food23
In EU legislation, only the limits established for AFB1 are mandatory, while the levels of DON, ZEN, OTA, T-2 and HT-2 toxins, and the sum of FB1 and FB2 are considered recommendations.
IMPACT OF MYCOTOXINS ON ANIMAL PRODUCTION
Fusarium and Alternaria mycotoxins are the most common mycotoxins in oats and can be present in feed products made from oats, affecting the health and performance of livestock.
Since these toxic compounds can cause various adverse effects in animals, the main mycotoxins of these genera and their consequences for animal health are detailed as follows.
Fusarium mycotoxins
Type A trichothecenes
Type A trichothecenes, such as T-2 and HT-2 toxin, are highly toxic to animals.
T-2 toxin, in particular, causes:
Reduction of food consumption
Weight loss
Oral necrosis
Internal hemorrhages in pigs and poultry
Damage in the gastrointestinal tract
In addition, it can cause immunosuppression, increasing susceptibility to infections, and can affect milk production in cows.
HT-2 toxin, although somewhat less toxic, also interferes with protein synthesis and affects immune function and animal growth, which may decrease productive efficiency24
Type B trichothecenes
DON and NIV are the main type B trichothecenes.
DON, known as “vomitoxin”:
Is widely recognized for inducing vomiting and feed refusal in pigs, which causes a decrease in weight gain.
Reduces feed efficiency and impairs immune response, increasing susceptibility to infections.
Alters the intestinal barrier, facilitating the entry of pathogens.
NIV, although less toxic than DON, also reduces growth in pigs and poultry and alters intestinal function, increasing the risk of infections and other digestive problems24
ZEN is a mycotoxin with estrogenic activity that can cause reproductive disorders in animals, especially in pigs.
Its toxicity is due to its ability to bind to estrogen receptors, generating endocrine, immunotoxic and carcinogenic effects.
In females, it causes:
Hyperestrogenism
Infertility
Vulvar enlargement
Abortions
In males, it:
Reduces semen quality
Affects testicular development
Reproductive problems have also been described in cattle and fish, where it reduces fertility, affects growth, and can accumulate in muscle25,26
Fumonisins
Fumonisins, especially FB1, interfere with sphingolipid metabolism, causing:
Leukoencephalomalacia in horses and pulmonary edema in pigs.
Hepatic and renal damage in various species.
Possible carcinogenic effects and metabolic alterations.
Hepatic and renal involvement in fish, where they reduce growth and feed consumption, alter feed conversion and may cause lesions in the brain and pancreas.
In general, these mycotoxins compromise health and productive performance, and increase mortality in exposed animals25,27
Alternaria mycotoxins
These mycotoxins have genotoxic, mutagenic, and carcinogenic effects in humans and animals28
Prolonged exposure may increase the risk of chronic diseases and affect DNA integrity.
TeA is a potent inhibitor of protein synthesis and is considered more toxic than AOH and AME.
It can cause alterations in cell metabolism and reduce feed efficiency in animals.
Although its toxicity in mammals is relatively low, TEN is a toxin that affects chloroplast development in plants.
Its impact on animals is minor compared to other Alternaria mycotoxins29
Emerging mycotoxins
Emerging mycotoxins recently detected in oats, such as NIV, DAS, enniatins, beauvericin, fusaric acid, fusarenon-X and sterigmatocystin, can have a variety of adverse effects on animal health.
These mycotoxins have the potential to affect the gastrointestinal and reproductive systems, feed conversion efficiency and can induce inflammatory processes.
It is important to consider possible synergistic or additive effects that may arise when interacting with already regulated mycotoxins30
METHODS OF ANALYSIS OF MYCOTOXINS IN OATS
Mycotoxin analysis in oats is essential to ensure food safety and compliance with current regulations.
Accurate detection of these compounds is a challenge due to their low concentration, heterogeneous distribution, and the presence of conjugated forms8,31
These toxins can affect grain quality and represent a risk to livestock health.
For this reason, various analytical methodologies are used that allow their identification and quantification with high sensitivity and specificity, thus ensuring feed safety1
Screening methods
These methods allow rapid and preliminary detection of mycotoxins in oats.
They are used to evaluate large sample volumes and provide rapid results, although with lower precision than chromatographic methods. These include1,32:
ELISA (Enzyme-linked immunoadsorbent assay): widely used method due to its speed and ease of use.
It is applicable for the detection of mycotoxins such as DON, ZEN, and OTA.
However, it may present interferences with the sample matrix, which affects the accuracy of the result.
Biosensors: they incorporate antibodies or aptamers that allow the detection of mycotoxins through optical or electrochemical signals.
They are an emerging technology with the potential to improve the speed and specificity of analysis, although they require more extensive validation before routine use.
Lateral flow devices: these are fast and portable detection tools, ideal for analysis in the field or in emergency conditions.
They work by detecting mycotoxins in a sample, generating a visual signal (as a colored line) on a test strip.
Although they are fast and easy to use, their sensitivity and accuracy can be inferior to more advanced methods, so they are generally used for initial screening.
Chromatographic methods
These methods offer greater accuracy and specificity in the detection of mycotoxins, although they require specialized equipment and longer analysis time1,32
High performance liquid chromatography (HPLC): technique widely used in the determination of mycotoxins.
It is used with UV, fluorescence detectors (FLD) or coupled to mass spectrometry (MS), allowing the simultaneous detection of multiple mycotoxins.
Its main advantage is the accuracy and sensitivity of detection.
Gas chromatography (GC-MS): mainly used for volatile mycotoxins or those requiring prior derivatization.
Although it offers high sensitivity, its application is more limited due to the complexity of the analytical procedure.
Non-invasive methods
New techniques are currently being explored for the detection of mycotoxins in oats without the need for destructive sample preparation33,34,35,36
An example of this is near infrared spectroscopy (NIR).
This technique allows the detection of mycotoxins quickly and without sample destruction, which makes it ideal for real-time analysis.
However, it requires specific calibrations and may be affected by matrix variability, which limits its applicability in some cases.
CONCLUSION
Monitoring and control of Fusarium and Alternaria mycotoxins in oats for animal feed is critical, as their presence can affect the health and performance of livestock.
The choice of analysis method depends on factors such as the type of mycotoxin, the required sensitivity, and the available infrastructure.
While screening methods such as ELISA, lateral flow devices and biosensors allow rapid and preliminary detection, chromatographic techniques remain the gold standard for their accuracy and ability to detect multiple mycotoxins.
The development of new technologies, such as advanced biosensors and spectroscopic techniques, opens new possibilities for improving the speed and accessibility of analysis.
As these tools evolve, their integration into automated systems will facilitate more efficient control.
Although the analysis of Fusarium and Alternaria mycotoxins in feed is not mandatory, their implementation is recommended due to their high frequency in oats and their negative effects on animals, thus contributing to a safer and more sustainable production.
Likewise, it is important to control different emerging mycotoxins that have been detected in oats in recent years so that they do not affect animal production.
BIBLIOGRAPHY
1. C. S. Pereira, S. C. Cunha, and J. O. Fernandes, “Prevalent mycotoxins in animal feed: Occurrence and analytical methods,” Toxins, vol. 11, no. 5, p. 290, 2019. DOI: 10.3390/toxins11050290.
2. G. F. Alemayehu, S. F. Forsido, Y. B. Tola, and E. Amare, “Nutritional and phytochemical composition and associated health benefits of oat (Avena sativa) grains and oat-based fermented food products,” Biomolecules, vol. 13, no. 5, p. 730, 2023. DOI: 10.1155/2023/2730175.
3. S. Marin, A. J. Ramos, G. Cano-Sancho, and V. Sanchis, “Mycotoxins: Occurrence, toxicology, and exposure assessment,” Food and Chemical Toxicology, vol. 62, pp. 59–75, 2013. DOI: 10.1016/j.fct.2013.07.047.
4. A. Bjørnstad and H. Skinnes, “Resistance to Fusarium infection in oats (Avena sativa L.),” Cereal Research Communications, vol. 36, no. 1, pp. 57–62, 2008. DOI: 10.1556/CRC.36.2008.Suppl.B.9.
5. L. De Colli et al., “Natural co-occurrence of multiple mycotoxins in unprocessed oats grown in Ireland with various production systems,” Toxins, vol. 13, no. 3, p. 188, 2021. DOI: 10.3390/toxins13030188.
6. N. Daud et al., “Free and modified mycotoxins in organic and conventional oats (Avena sativa L.) grown in Scotland,” Toxins, vol. 15, no. 4, p. 247, 2023. DOI: 10.3390/toxins15040247.
7. A. Tarazona, J. V. Gómez, F. Mateo, M. Jiménez, and E. M. Mateo, “Potential health risk associated with mycotoxins in oat grains consumed in Spain,” Toxins, vol. 13, no. 6, p. 421, 2021. DOI: 10.3390/toxins13060421.
8. I. Teixido-Orries et al., “Mapping variability of mycotoxins in individual oat kernels from batch samples: Implications for sampling and food safety,” Toxins, vol. 17, no. 1, p. 34, 2025. DOI: 10.3390/toxins17010034.
9. W. Yan, D. Pageau, R. Martin, A. Cummiskey, and B. Blackwell, “Is deoxynivalenol contamination a serious problem for oat in eastern Canada?,” Crop Science, vol. 57, no. 1, pp. 88–98, 2017. DOI: 10.2135/cropsci2016.04.0263.
10. E. Fredlund et al., “Deoxynivalenol and other selected Fusarium toxins in Swedish oats—Occurrence and correlation to specific Fusarium species,” International Journal of Food Microbiology, vol. 167, no. 2, pp. 276–283, 2013. DOI: 10.1016/j.ijfoodmicro.2013.06.026.
11. A. Bernhoft, P. E. Clasen, A. B. Kristoffersen, and M. Torp, “Less Fusarium infestation and mycotoxin contamination in organic than in conventional cereals,” Food Additives and Contaminants - Part A, vol. 27, no. 6, pp. 842–852, 2010. DOI: 10.1080/19440041003645761.
12. J. Perkowski et al., “A comparison of contents of group A and B trichothecenes and microbial counts in different cereal species,” Food Additives and Contaminants - Part B: Surveillance, vol. 5, no. 3, pp. 151–159, 2012. DOI: 10.1080/19393210.2012.675591.
13. A. V. Nathanail et al., “Simultaneous determination of major type A and B trichothecenes, zearalenone, and certain modified metabolites in Finnish cereal grains with a novel liquid chromatography-tandem mass spectrometric method,” Analytical and Bioanalytical Chemistry, vol. 407, no. 16, pp. 4745–4755, 2015. DOI: 10.1007/s00216-015-8676-4.
14. I. Polišenská, O. Jirsa, K. Vaculová, M. Pospíchalová, S. Wawroszova, and J. Frydrych, “Fusarium mycotoxins in two hulless oat and barley cultivars used for food purposes,” Foods, vol. 9, no. 8, p. 1037, 2020. DOI: 10.3390/foods9081037.
15. T. Schöneberg et al., “Occurrence of Fusarium species and mycotoxins in Swiss oats—Impact of cropping factors,” European Journal of Agronomy, vol. 92, pp. 123–132, 2018. DOI: 10.1016/j.eja.2017.09.004.
16. A. S. Orina, O. P. Gavrilova, N. N. Gogina, P. B. Gannibal, and T. Y. Gagkaeva, “Natural occurrence of Alternaria fungi and associated mycotoxins in small-grain cereals from the Urals and West Siberia regions of Russia,” Toxins, vol. 13, p. 223, 2021. DOI: 10.3390/toxins.
17. I. Reinholds et al., “Mycotoxins in cereals and pulses harvested in Latvia by nanoLC-Orbitrap MS,” Food Additives and ContaminantsPart B: Surveillance, vol. 14, no. 2, pp. 115–123, 2021. DOI: 10.1080/19393210.2021.1892204.
18. B. Kosiak, M. Torp, E. Skjerve, and B. Andersen, “Alternaria and Fusarium in Norwegian grains of reduced quality - A matched pair sample study,” International Journal of Food Microbiology, vol. 93, no. 1, pp. 51–62, 2004. DOI: 10.1016/j.ijfoodmicro.2003.10.006.
19. J. C. Meyer, I. Hennies, D. Wessels, and K. Schwarz, “Survey of mycotoxins in milling oats dedicated for food purposes between 2013 and 2019 by LC–MS/MS,” Food Additives and Contaminants - Part A: Chemistry, Analysis, Control, Exposure and Risk Assessment, vol. 38,
no. 11, pp. 1934–1947, 2021. DOI: 10.1080/19440049.2021.1950931.
20. European Commission, “Commission directive 2003/100/EC of 31 October 2003 amending Annex I to Directive 2002/32/EC of the European Parliament and of the Council on undesirable substances in animal feed,” Official Journal of the European Union, vol. L285/33, 2003. Available: www.efsa.europa.eu.
21. European Commission, “Commission recommendation on the presence of deoxynivalenol, zearalenone, ochratoxin A, T-2 and HT-2 and fumonisins in products intended for animal feeding,” Official Journal of the European Union, vol. L229/7, 2006. Available: www.efsa. europa.eu.
22. European Commission, “Commission recommendation of 27 March 2013 on the presence of T-2 and HT-2 toxin in cereals and cereal products,” Official Journal of the European Union, vol. L, no. 91, pp. 12–15, 2013. DOI: 10.2903/j.efsa.2011.2481.
23. European Commission, “Commission recommendation (EU) 2016/1319 of 29 July 2016 amending Recommendation 2006/576/EC as regards deoxynivalenol, zearalenone and ochratoxin A in pet food,” Official Journal of the European Union, vol. 208, pp. 58–60, 2016. Available: www.efsa.europa.eu.
24. M. Polak-Śliwińska and B. Paszczyk, “Trichothecenes in food and feed, relevance to human and animal health and methods of detection: A systematic review,” Molecules, vol. 26, no. 2, p. 454, 2021. DOI: 10.3390/molecules26020454.
25. M. E. Bezerra da Rocha, F. F. da Chagas Oliveira, F. E. Feitosa Maia, M. I. Florindo Guedes, and D. Rondina, “Mycotoxins and their effects on human and animal health,” Food Control, vol. 35, pp. 208–219, 2014. DOI: 10.1016/j.foodcont.2013.08.021.
26. R. A. Gonçalves, K. Naehrer, and G. A. Santos, “Occurrence of mycotoxins in commercial aquafeeds in Asia and Europe: A real risk to aquaculture?,” Risk Analysis Quarterly, vol. 51, no. 6, pp. 1313–1325, 2018. DOI: 10.1111/raq.12159.
27. R. A. Gonçalves, J. Dias, and D. Schatzmayr, “Effect of low levels of fumonisin contamination on gilthead seabream (Sparus aurata),” Journal of World Aquaculture Society, vol. 51, no. 6, pp. 1313–1325, 2020. DOI: 10.1111/jwas.12730.
28. J. Alexander et al., “Scientific Opinion on the risks for animal and public health related to the presence of Alternaria toxins in feed and food,” EFSA Journal, vol. 9, no. 10, p. 2407, 2011. DOI: 10.2903/j.efsa.2011.2407.
29. J. Lou, L. Fu, Y. Peng, and L. Zhou, “Metabolites from Alternaria fungi and their bioactivities,” Molecules, vol. 18, no. 5, p. 5891, 2013. DOI: 10.3390/molecules18055891.
30. O. Kolawole, W. Siri-Anusornsak, A. Petchkongkaew, and C. Elliott, “A systematic review of global occurrence of emerging mycotoxins in crops and animal feeds, and their toxicity in livestock,” 2024, KeAi Communications Co. doi: 10.1016/j.emcon.2024.100305.
31. S. A. Tittlemier and T. B. Whitaker, “Current sampling plans can introduce high variance in mycotoxin testing results as demonstrated by the online FAO Mycotoxin Sampling Tool,” World Mycotoxin Journal, vol. 16, no. 2, pp. 115–126, 2023. DOI: 10.3920/WMJ2022.2804.
32. K. M. Koczula and A. Gallotta, “Lateral flow assays,” Essays in Biochemistry, vol. 60, no. 1, pp. 111–120, 2016. DOI: 10.1042/ EBC20150012.
33. I. Teixido-Orries, F. Molino, F. Gatius, V. Sanchis, and S. Marín, “Near-infrared hyperspectral imaging as a novel approach for T-2 and HT-2 toxins estimation in oat samples,” Food Control, vol. 153, p. 109952, 2023. DOI: 10.1016/j.foodcont.2023.109952.
34. I. Teixido-Orries, F. Molino, A. Femenias, A. J. Ramos, and S. Marín, “Quantification and classification of deoxynivalenol-contaminated oat samples by near-infrared hyperspectral imaging,” Food Chemistry, vol. 375, p. 135924, 2023. DOI: 10.1016/j.foodchem.2023.135924.
35. S. Tekle, I. Mage, V. H. Segtnan, and A. Bjornstad, “Near-infrared hyperspectral imaging of Fusarium-damaged oats (Avena sativa L.),” Cereal Chemistry, vol. 92, no. 1, pp. 73–80, 2015. DOI: 10.1094/CCHEM-04-14-0074-R.
36. S. Tekle, Å. Bjørnstad, H. Skinnes, Y. Dong, and V. H. Segtnan, “Estimating deoxynivalenol content of ground oats using VIS-NIR spectroscopy,” Cereal Chemistry, vol. 90, no. 3, pp. 181–185, 2013. DOI: 10.1094/CCHEM-07-12-0084-R.